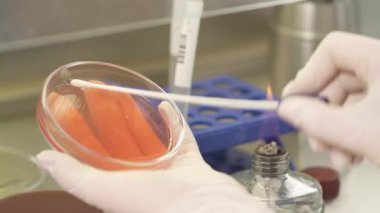
Steril pamuklu bilim adamı tarım petri kabından bakteri topluyor. Yakın çekim gösteri videosu

İhlal Bildirim Formu
En Çok Aranan Kelimeler
beyazdonanımkişiKadın.insanlarSıvıSağlıkkanİlaç.Sağlık hizmetleriTıbbieczaneEl.sanayiKlinikDoktorKadınçalışmaTest etTüpkoruyucuHastalıkörnekbiyolojiKimyasalKimyagerDeneyLaboratuvarBilimanalizvirüskimyaMaddehortumuMaskeEczacılık.araştırmaBilimselİncelemebiyokimyaBiyoteknoloji.bilim adamıPratisyenMikrobiyolojiBenzer İçerikler